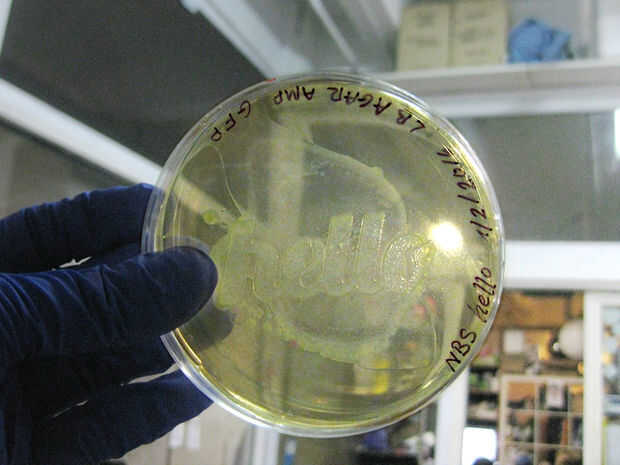

Paso 10: incubación
Coloque la placa en un * incubadora de 37° C por 1 ó 2 días para las colonias de bacterias desarrollar.
(Algunos microbios requieren incubadora de 30° C, compruebe sus protocolos)
Después de 1 o 2 días las colonias de las bacterias han desarrollado y se verá
crecimiento sobre las áreas expuestas del agar donde los microbios podrían fácilmente festín de sus nutrientes favoritos.













